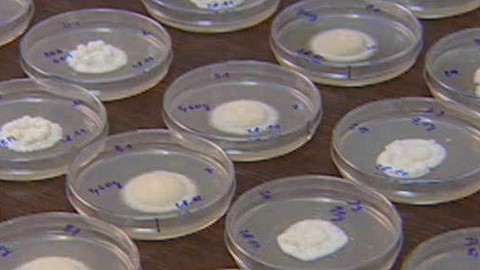
Přidej se - Kůrovec a ekologické metody likvidace

14 minut
Přidej se
Soukromé rezervace
Obsah dílu
Jak si pár nadšenců pronajalo lužní les
ČT nemá práva pro internet
Stopáž15 minut
Kůrovec a ekologické metody likvidace
Přehled dílů
102 přehratelných

Stopáž14 minut
Přidej se
Jaké omyly a předsudky jsou spojené s žábami a co je potřeba k jejich ochraně?
Poslední vysílání 24. 6. 2025 na ČT2

Stopáž15 minut
Přírodní bohatství Písecka
Očima zoologa a cestovatele RNDr. Karla Pecla
Poslední vysílání 23. 8. 2024 na ČT2

Stopáž15 minut
Profesor Erazim Kohák
Jaké názory o životním prostředí si ze světa do České republiky přivezl?
Poslední vysílání 31. 5. 2024 na ČT2

Stopáž14 minut
Hraniční meandry Odry
Meandry u Bohumína jsou naprostým přírodním unikátem, který si zaslouží ochranu
Poslední vysílání 2. 5. 2025 na ČT2

Stopáž10 minut
Přírodní zahrady IV.
Wernerova podhorská zahrada
Poslední vysílání 30. 12. 2012 na ČT2

Stopáž10 minut
Přírodní zahrady III.
Rakousko
Poslední vysílání 23. 12. 2012 na ČT2

Stopáž10 minut
Řeka se dřevem
Jak na dně Odry leží stromy ze včerejška i staré tisíce let
Poslední vysílání 21. 5. 2020 na ČT2

Stopáž10 minut
Zeleninová a bylinková zahrada bez chemie
Zahrada Tiree Chmelar ve Valticích
Poslední vysílání 9. 12. 2012 na ČT2

Stopáž10 minut
Přírodní zahrady II.
Rybníček v Plavsku
Poslední vysílání 2. 12. 2012 na ČT2

Stopáž10 minut
Přírodní zahrady I.
Bylinková vesnička Mutišov
Poslední vysílání 25. 11. 2012 na ČT2



